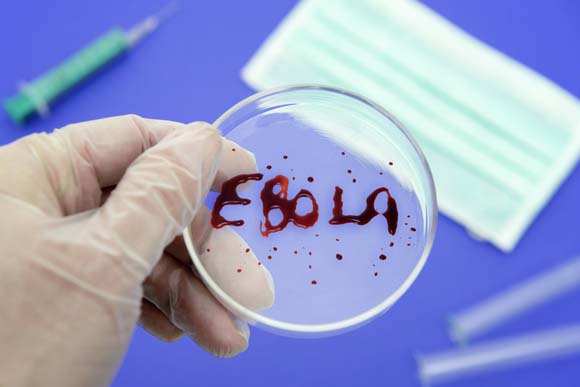

还有不到半个月,我们就将送走2014,搜索巨头Google也适时公布了本年度热门搜索榜单。本次榜单汇集了全球72个国家和地区的热门人物和事件,统计的搜索次数超过2万亿次。其中全球十大热词如下:
1,罗宾·威廉姆斯
今年离开这个世界的名人不少,而出演过《死亡诗社》和《心灵捕手》等多部经典影片的威廉姆斯能排在年度搜索词榜首,说明了他在观众心中的位置。在银幕上带给观众欢乐和思考的威廉姆斯近来一直在与严重的抑郁症作斗争,他的去世也引发了人们对这种神秘疾病的关注和讨论。

2,FIFA世界杯
让球迷苦等了四年的体育盛事在今年夏天给人们留下了深刻印象,创下多项新纪录,比如新的门线技术。德国队表现出色,在半决赛以7:1让东道主巴西队蒙羞,最终击败阿根廷夺冠。而在巴西国内,部分民众抗议政府把应该用在改善医疗、教育、交通和住房方面的巨额资金浪费在面子工程上。

3,埃博拉病毒

这种缘于非洲的传染病造成全球性大恐慌,人们纷纷搜索如何防范的信息。今年,埃博拉疫情首次扩散至非洲以外,而发达国家和民众对埃博拉疫情一直未予足够重视。埃博拉所引起的恐慌,也成为了全球股市一度暴跌的导火索之一。最近,《时代》周刊也把抗埃博拉斗士评选为年度人物。
4,马航MH370
2014年3月8日凌晨,马航MH370在马来西亚与越南的雷达覆盖边界与空中交通管制失去联系,原定由吉隆坡飞往北京。坠机事件引发全球,尤其是中国媒体的高度关注。经过半个月的多方密集搜救后,官方证实其坠入南印度洋,航班上载有227名乘客(包括中国内地153人)和机组人员12名几乎没有生存的可能。现在,全世界还在继续搜寻它的下落。

5,ALS(肌萎缩侧索硬化)
由肌萎缩侧索硬化发起的“冰桶挑战”在今年夏天引发社交网络病毒式传播,也确实在促进人们关注这种疾病上起到积极的作用。但也有批评者指出,这个极受欢迎活动的背后并不完全是利他主义,名人的炒作目的多于公益层面。

6,《Flappy Bird》
这款由越南独立游戏开发者阮哈东设计的通关游戏打败了《使命召唤11:高级战争》、《FIFA 15》、《命运》等高成本制作,成为今年最受网友关注的游戏。今年 2 月份,阮哈东对这款游戏的成瘾性感到内疚,因此决定下架该游戏,这反倒使这款游戏突然爆红。

7,肯奇塔·沃斯特(Conchita Wurst)
这位奥地利易装男歌手5月份在欧洲歌唱大赛中夺冠,整个世界都为之疯狂,其Twitter、Facebook 和 Instagram 信息页的搜索量也一路飙涨。由于不男不女的装扮,他在奥地利国内引起了公众有史以来最大的愤怒,也引起了拥有保守传统观念的白俄罗斯的全面抵制。

8,ISIS
这个活跃在伊拉克和叙利亚的极端恐怖组织,实施造成大量死伤的多重暴力活动,让包括美国和欧盟、北约以及阿盟等地区组织在内的国际联盟焦头烂额。更令世人恐惧的是,该组织通过一系列令人震惊的品牌营销策略与社交媒体手段在全球拥有一定的追随者。

9,《冰雪奇缘》
这部迪士尼公司成立90周年纪念作品去年底上映,它豪取12.7亿美元的票房,成为全球动画史票房冠军,被戏谑为“洗脑歌”的原声歌曲《Let it go》至今仍在Billboard、UK榜等榜单上表现强势。其线下产品也很欢迎,父母们争相为女儿购买片中公主的裙子。

10,索契冬奥会
相对于精彩绝伦的运动会本身,500亿美元建设投入、官方关于同性恋话题的禁令、俄罗斯入侵克里米亚、斯诺登事件等政治话题更为引发外界关注。




评论